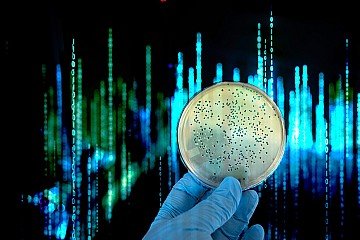
Press Release cover image

I'm always excited to hear about different learning techniques. So when I started to read 'The Lean Startup' by Eric Ries, and got to the bit about Validated Learning, I thought I have to include it here.
Validated Learning different from other types of learning because it emphasizes a scientific, experimental approach to testing and validating assumptions and hypotheses.
In his bestseller, Eric defines Validated Learning (VL) as the process of testing and (unsurprisingly) validating assumptions and hypotheses through experimentation in order to make informed decisions and improve a product or business.
It's a key ingredient of successful startups which emphasises a scientific approach to entrepreneurship.
The concept of VL works by systematically testing assumptions and gathering data to either confirm or disprove them. Are your ideas good or bad?
With VL entrepreneurs can make decisions based on real evidence, rather than intuition or guesswork.
The process involves creating hypotheses, designing experiments to test those hypotheses, measuring the results (eg. by customer feedback), and then using the results to inform the next round of hypotheses and experiments.
This can save a lot of wasted time, effort and money.
One example from the book is a startup which wants to launch a new mobile app: Before investing a significant amount of time and money into building the app, the startup can use validated learning to test their assumptions about the target market and the features of the app. They can create a landing page with a sign-up form to gauge interest and collect email addresses of potential users. Then, they can send targeted ads to different demographics to see which groups are most interested in the app.
Then based on the data collected, they can refine their assumptions and develop the app in a way that better meets the needs of their target audience.
This saves them the frustration of spending thousands of hours creating code for features nobody is interested in.
Another example is a company that wants to improve their customer service: They could test the hypothesis that customers would be more satisfied if they were offered a personalized experience. The company could create a survey to ask customers for feedback on their experiences, then segment the responses to see if there is a difference in satisfaction levels between customers who received a personalized experience and those who did not. The company could use this data to inform changes in their customer service approach and improve customer satisfaction.
Validated Learning takes the guesswork out of creating a new product (service or business) by using data and evidence to guide decision-making and improve a product or business. Thus, by testing assumptions and hypotheses, entrepreneurs can make more informed decisions and reduce the risk of failure.